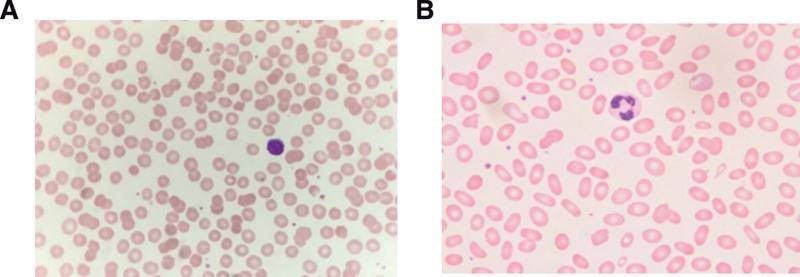

台湾地区一个遗传性球形红细胞增多症大家族和一例罕见的遗传性椭圆形红细胞增多症伴新型 SPTA1 突变病例:病例报告及文献复习。
A large family of hereditary spherocytosis and a rare case of hereditary elliptocytosis with a novel SPTA1 mutation underdiagnosed in Taiwan: A case report and literature review.
机构信息
Division of Hematology-Oncology, Changhua Christian Hospital, Changhua City, Taiwan.
Department of Research, Changhua Christian Hospital, Changhua City, Taiwan.
出版信息
Medicine (Baltimore). 2023 Jan 27;102(4):e32708. doi: 10.1097/MD.0000000000032708.
RATIONALE
Hereditary spherocytosis (HS) has a defect in the vertically connected proteins on the cell membrane of red blood cells (RBC). Hereditary elliptocytosis (HE) has a defect in proteins that connect the cell membrane horizontally. We reported two families of RBC membrane disorders in Taiwanese, one was HS and the other was HE.
PATIENT CONCERNS
Case 1. A 19-year-old male student with chronic jaundice and splenomegaly. His mother, maternal uncle, grandmother, and many members of older generations also had splenomegaly and underwent splenectomy. Case 2. A 40-year-old man has experienced pallor and jaundice since the age of 20 and was found to have splenomegaly, and gall bladder stones in the older age. His younger sister also had pallor and jaundice for a long time.
DIAGNOSES
In case 1, a peripheral blood smear showed 20% spherocytes. Eosin-5-maleimide labeled RBC by flow cytometry showed a result of 30.6 MCF (cutoff value: 45.5 MCF). He was diagnosed with HS. The gene analysis identified a heterozygous mutation with c.166A > G (p.Lys56Glu) in the SLC4A1 gene in this proband, his mother, and maternal uncle. In case 2, more than 40% of ellipsoid RBC present in the peripheral blood smear. He was diagnosed with HE. Genetic analysis of the SPTA1 gene identified a novel heterozygous exon2, c.86A > C, p.Gln29Prol mutation.
INTERVENTIONS
The two patients had compensated anemia, clinical follow-up instead of splenectomy was done.
OUTCOMES
The two patients had normal daily activities and lives.
LESSONS
We reported two Taiwanese families, one was hereditary spherocytosis affected by a heterozygous mutation with c.166A > G (p.Lys56Glu) in SLC4A1, and the other was hereditary elliptocytosis caused by a novel heterozygous SPTA1 gene mutation, c. 86A > C, p.Gln29Prol. These 2 seemingly common hereditary red blood cell membrane protein defects induced by hemolysis are usually underdiagnosed or misdiagnosed.
背景
遗传性球形红细胞增多症(HS)是红细胞膜上垂直连接蛋白的缺陷。遗传性椭圆形红细胞增多症(HE)是细胞膜水平连接蛋白的缺陷。我们在台湾报道了两个红细胞膜疾病家族,一个是 HS,另一个是 HE。
病例 1:一名 19 岁男性学生,有慢性黄疸和脾肿大。他的母亲、舅舅、祖母和许多老一辈人也有脾肿大,并接受了脾切除术。
病例 2:一名 40 岁男子自 20 岁以来出现苍白和黄疸,并发现脾肿大,老年时还有胆囊结石。他的妹妹也长期苍白和黄疸。
诊断
在病例 1 中,外周血涂片显示 20%的球形红细胞。通过流式细胞术用伊文思蓝-5-马来酰亚胺标记 RBC 的结果为 30.6 MCF(临界值:45.5 MCF)。他被诊断为 HS。基因分析发现该先证者及其母亲和舅舅的 SLC4A1 基因存在 c.166A > G(p.Lys56Glu)杂合突变。在病例 2 中,外周血涂片显示超过 40%的椭圆形 RBC。他被诊断为 HE。SPTA1 基因的遗传分析发现了一个新的杂合外显子 2,c.86A > C,p.Gln29Pro 突变。
干预措施
两名患者均为代偿性贫血,行临床随访而非脾切除术。
结果
两名患者的日常生活和活动均正常。
教训
我们报道了两个台湾家庭,一个是由 SLC4A1 基因的 c.166A > G(p.Lys56Glu)杂合突变引起的遗传性球形红细胞增多症,另一个是由 SPTA1 基因的 c.86A > C,p.Gln29Pro 新的杂合突变引起的遗传性椭圆形红细胞增多症。这些 2 个看似常见的遗传性红细胞膜蛋白缺陷引起的溶血性疾病通常被漏诊或误诊。